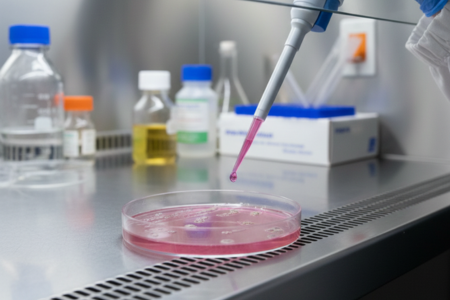

Sterility and packaging for sterile micropipette tips
Sterile tips require gamma irradiation or other sterilization processes, specialized clean-room packaging, and validation testing that roughly doubles the cost versus non-sterile tips. Sterility matters for cell culture and microbiology but provides no benefit for analytical chemistry or molecular biology where reagents arrive sterile.
Filter barriers in micropipette filter tips
Adding filter membranes to prevent aerosol contamination increases manufacturing complexity and material costs, typically doubling the price versus standard tips. Filters are essential for PCR and RNA work but unnecessary for buffer prep and routine chemistry where cross-contamination isn't a concern.
Brand premium and marketing
Major pipettor manufacturers charge premium prices for tips partly due to brand reputation and marketing costs, but primarily because they profit from consumables sales. The "optimized for our pipettors" claim drives sales but doesn't reflect meaningful performance differences for routine applications. Universal disposable micropipette tips from qualified manufacturers perform identically for standard work.
Low-retention coatings
Hydrophobic surface treatments that reduce sample retention add material and processing costs. These coatings genuinely help with viscous or expensive samples but provide no benefit for typical aqueous solutions that represent most lab pipetting.
Quality control and certification
Extensive lot testing, contamination certification, and regulatory documentation add costs that some applications require and others don't. Clinical diagnostics or pharmaceutical QC may need this documentation, while academic research typically doesn't.
Volume and packaging
Bulk packaging (960-count racks vs 96-count) reduces per-tip cost but requires larger upfront purchases and storage space. Consider your consumption rate and available storage when evaluating packaging options.